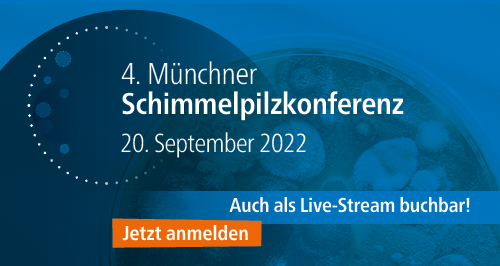

RM-Seminarprogramm
Kursthemen
-
-
Hier können Sie alle Ihre Fragen rund um unser Seminarprogramm stellen.
-

Online-Seminar, 23.08.2022, 09:30 - 15:30 Uhr
Das Online-Seminar liefert Planern*innen und Vertretern*innen der Bauaufsicht Grundlagewissen für die brandschutztechnisch sichere Planung und Ausführung von mehrgeschossigen Holzgebäuden. Neben der bauordnungsrechtlichen Ist-Situation wird den Teilnehmern*innen ein tiefergehendes Hintergrundwissen zu notwendigen konstruktiven Maßnahmen, zum Stand der Technik und zur brandschutztechnischen Planung von mehrgeschossigen Holzgebäuden mit Blick auf aktuelle Forschungsergebnisse vermittelt.
Weitere Informationen zum Programm finden Sie hier.
Sie wollen sich direkt anmelden? Hier geht es zur Anmeldung!
-
 Livestream, 28.09.2022, 09:00 - 17:00 Uhr
Livestream, 28.09.2022, 09:00 - 17:00 UhrDie Fachtagung informiert über aktuelle Themen, Trends und Konzepte zum barrierefreien, demografiefesten Bauen und bietet Ihnen eine Plattform, sich mit Fachexpertinnen und Experten auszutauschen.
Weitere Informationen zum Programm finden Sie hier.
Sie wollen sich direkt anmelden? Hier geht es zur Anmeldung! -
 Livestream, 15. November 2022, 09:00 -17:00 Uhr
Livestream, 15. November 2022, 09:00 -17:00 UhrWir bringen Planerinnen und Experten aus Brandschutz und Barrierefreiheit an einen Tisch. Denn gerade bei den Themen Brandschutz & Barrierefreiheit prallen widersprüchliche Anforderungen und Schutzziele aufeinander. Der barrierefreie Brandschutz in Deutschland steckt noch in den Kinderschuhen und gelungene Beispiele aus der Praxis sind Mangelware. Weitere Informationen zum Programm finden Sie hier. Sie wollen sich direkt anmelden? Hier geht es zur Anmeldung!
-
 Online-Seminar mit sechs Modulen (einzeln buchbar), 29. November - 8. Dezember 2022
Online-Seminar mit sechs Modulen (einzeln buchbar), 29. November - 8. Dezember 2022Behindertenbeauftrage werden im Rahmen von Bauprojekten und städtebaulichen Planungen immer häufiger um Stellungnahmen gebeten. Grundlage sind meist Genehmigungsunterlagen, Pläne und Konzepte oder Begehungen vor Ort. Die in der Regel „baufremden“ Behindertenbeauftragten stehen dabei vor der Herausforderung, die vorgelegten Planungen und Bauprojekte richtig einschätzen und verstehen zu können. Weitere Informationen zum Programm finden Sie hier. Sie wollen sich direkt anmelden? Hier geht es zur Anmeldung!
-
-
Livestream, 20.09.2022, 09:00 - 17:00 Uhr
Livestream, 20.09.2022, 09:00 - 17:00 UhrSchimmelpilze in Gebäuden sind ein wichtiges Dauerthema und regelmäßig Anlass für Konflikte, nicht nur in älteren Bestandsbauten, sondern auch in energetisch sanierten Gebäuden und Neubauten. Dabei sind die Ursachen von mikrobiellen Schäden genauso vielfältig wie die Probleme, die sie mit sich bringen können.
Weitere Informationen zum Programm finden Sie hier. Sie wollen sich direkt anmelden? Hier geht es zur Anmeldung für die Präsenzveranstaltung! -
 Online-Seminar, 22.09.2022, 09:30 - 13:00 Uhr
Online-Seminar, 22.09.2022, 09:30 - 13:00 UhrDas Intensivseminar dient der Vermittlung oder Auffrischung von berufsorientiertem Grundwissen mit einem Blick auf die Ganzheitlichkeit der Brandschutzplanung im Bestand. Sie erhalten einen fundierten Überblick über die brandschutzrelevanten Baubestimmungen und besprechen gemeinsam mit dem Referenten Praxisbeispiele aus den Bereichen Sanierung und Denkmalpflege.
Weitere Informationen zum Programm finden Sie hier.
Sie wollen sich direkt anmelden? Hier geht es zur Anmeldung! -

Livestream 22.09.2022-23.09.2022
EASTWOOD ist der neue Holzbau-Kongress der Forschungsgruppe FLEX an der HTWK Leipzig und der Rudolf Müller Mediengruppe. Im Fokus steht der Ausbau einer interaktiven Plattform in Anlehnung an einen immer digitaler werdenden Markt. Dahinter steht die feste Überzeugung, dass eine gute Konzeption die unbedingte Voraussetzung für ein ressourceneffizientes Bauen ist.
Weitere Informationen zum Programm finden Sie hier.
Sie wollen sich direkt anmelden? Hier geht es zur Anmeldung! -
Online-Seminar, 28.09.2022, 14:00 - 16:00 Uhr
Das Online-Seminar vermittelt den Teilnehmer*innen Basiswissen zum abfall- und gefahrschutzrechtlich gebotenen Umgang mit Asbest auf der Baustelle. Dargestellt werden sowohl die Vorgaben zur Erkundung und Entsorgung aus den einschlägigen Gesetzen als auch aus dem untergesetzlichen Regelwerk wie etwa der aktuellen Leitlinie zur Asbesterkundung bei Arbeiten an älteren Gebäuden, der neuen Asbest-Richtlinie und der neuen LAGA – “Vollzugshilfe zur Entsorgung asbesthaltiger Abfälle – M 23”. Es greift insbesondere abfallrechtliche Aspekte des Umgangs mit Asbest im Baustellenalltag auf.
Weitere Informationen zum Programm finden Sie hier.
Sie wollen sich direkt anmelden? Hier geht es zur Anmeldung! -
Online-Seminar, 26.10.2022, 09:30 - 13:00 Uhr
Im Seminar werden die wichtigsten Inhalte eines Brandschutznachweises vermittelt. Anhand von Praxisbeispielen wird erklärt, wie Planende bei der Erstellung des Nachweises vorgehen können, um genehmigungsfähige, mangelfreie und für die weiteren Bauphasen gut verwendbare Unterlagen zu erarbeiten.
Weitere Informationen zum Programm finden Sie hier.
Sie wollen sich direkt anmelden? Hier geht es zur Anmeldung! -
Online-Seminar, 02.11.2022, 09:30 - 13:00 Uhr
Das Intensivseminar behandelt Grundlagen zum Brandschutz und Bestandsschutz: Entstehen und Erlöschen von Bestandsschutz, Verkehrssicherungspflicht und Denkmalschutz. Der Brandschutz im Bestand verlangt wie kaum ein anderes Thema einen behutsamen Umgang mit der vorhandenen Bausubstanz im Spannungsfeld zwischen Gebäudesicherheit und Wirtschaftlichtkeit. Das Seminar vermittelt anhand der Rechtsprechung und Fallbeispielen aus der Beratungspraxis des Referenten die rechtlichen Grundlagen und die Systematik der bauordnungsrechtlichen Vorschriften zum Bestandsschutz.
Weitere Informationen zum Programm finden Sie hier.
Sie wollen sich direkt anmelden? Hier geht es zur Anmeldung! -
Online-Seminar, 03.11.2022, 10:00 - 15:30 Uhr
Die Inhalte des Seminars sind u.a. die aktuellen gesetzlichen und normativen Entwicklungen, die für die Erstellung und Fortschreibung von Brandschutzordnungen relevant sind. Behandelt werden praxisrelevante Hinweise zum Stand der Vorschriften für Brandschutzordnungen nach DIN 14096.
Weitere Informationen zum Programm finden Sie hier.
Sie wollen sich direkt anmelden? Hier geht es zur Anmeldung! -
Online-Seminar, 16.11.2022, 09:30 - 13:00 Uhr
Gegenstand des Seminars ist die Vertiefung von rechtlichen Grundkenntnissen zum Brandschutz im Bestand. Die Vertiefung erfolgt anhand von typischen Fragestellungen aus der Rechtsprechung und der Beratungspraxis des Referenten.
Weitere Informationen zum Programm finden Sie hier.
Sie wollen sich direkt anmelden? Hier geht es zur Anmeldung! -
Online-Seminar, 22.11.2022, 09:30 - 15:30 Uhr
Das Seminar behandelt die brandschutztechnisch sichere Planung und Ausführung von mehrgeschossigen Holzgebäuden. Das Online-Seminar liefert Planern*innen und Vertretern*innen der Bauaufsicht Grundlagenwissen für die brandschutztechnisch sichere Planung und Ausführung von mehrgeschossigen Holzgebäuden. Neben der bauordnungsrechtlichen Ist-Situation wird den Teilnehmern*innen ein tiefergehendes Hintergrundwissen zu notwendigen konstruktiven Maßnahmen, zum Stand der Technik und zur brandschutztechnischen Planung von mehrgeschossigen Holzgebäuden mit Blick auf aktuelle Forschungsergebnisse vermittelt.
Weitere Informationen zum Programm finden Sie hier.
Sie wollen sich direkt anmelden? Hier geht es zur Anmeldung!